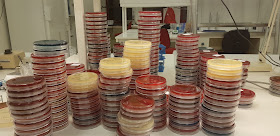

Anne Lindmo lanserte fødedagen på Facebook for ei stund sidan, og idag føler eg for å feire den litt. (men eg klarer ikkje linke til innlegget på Facebook, så det må du søke opp sjøl) Jada, junior fyller 22 år, men jammen gjorde eg ein jobb!
Då eg kjente at noko var i ferd med å skje på kvelden den 22.oktober for 22 år sidan, vart eg litt forvirra. Det var ei veke igjen til termin, og var det ein ting eg hadde lært i løpet av dette mitt første svangerskap var det at ingen føder før tida! (men spør meg gjerne om min andre fødsel...den kom ikkje før termin) Mannen bakte brød, og sidan vi viste at dette skulle ta si tid, bakte han ferdig, snakka med bror sin på telefon "Neida, her er alt roleg"; sa mannen, medan eg låg over armlenet på sofaen og tok tida på veene. Det var forsåvidt roleg, det gjekk ikkje lynraskt. Svogeren min ante fred og ingen fødsel, og det var planen vår. Ingen viste noko då vi tok med oss bagen og reiste på sjukehuset rundt midnatt.
Funfact: dette var i gamle dager, og vi hadde ikkje mobiltelefon(vi kjøpte ein då vi skulle kjøre 35 mil på julebesøk, eg syns det var veldig rart å ha mobil og ringte aldri slik at nokon såg det. Eg har endra meg, for å seie det slik). Men vi hadde nyinnkjøpt kompaktkamera, med ferske batteri og ny film.
På sjukehuset fekk vi rom, og ting gjekk heller sakte framover, mannen prøvde sove i ein stol og eg veksla mellom dusj og seng, lite kvile i noko som helst. Mannen masserte ryggen og trøsta og oppmuntra, og innimellom syns eg både han og jordmor var heller dumme og håplause. Men eit vagt blaff av fornuft gjorde at eg ikkje sendte dei på dør. Å vere medhjelpar til ein fødsel kan ikkje vere så greit! Det var jordmor og jordmorstudent og ein eller annan gong var det ein lege innom, alle var opptekne av god folkeskikk og handhelsa. Akkurat det var litt vekk-kasta, eg huskar lite av det. Utpå morgonen var det vaktskifte, og ny jordmor og legestudent -og eg huskar endå mindre anna enn at eg syns det gjekk sakte, eg var trøytt, at lystgassen ikkje virka/eg ikkje klarte bruke den og at petidin, den gong eit vidundermiddel, ikkje var greit. Petidin gjekk ut av bruk ganske snart, for dei stakkars babyane var sløve etter fødsel.
Tilslutt kom junior, litt sliten og blå, men han kom seg fort. Den kloke, fine, flotte legestudenten sa at dette var det finaste barnet ho hadde sett (det var vel hennar første fødsel, men pytt) og slikt gleder ei nybakt mor å høre.
Klokka 10.34 var han der, arvingen, den førstefødte, han vi både kjente og ikkje kjente. Ein fin fyr, mørkt hår, store, mørke auger og litt gulsott(som gjorde han gylden i huda) Ein liten kar som slett ikkje hadde tenkt å sove bort tida. Som ville ligge tett inntil, som fekk det, for han var den nye sjefen. Det er ei av dei hendingane som har snudd mest opp ned på livet mitt! Sove? "MAT" sa junior. Ut på tur? Bleieskift først. Sove? Nei, selskap er artigare. Og så vidare...
Han hadde gitt meg si første vakenatt. Det har vorte fleire med åra, både med "nattmatservering" og med venting på at han skal kome heim. Eg var sliten, og det er vel denne jobben eg syns eg kan feire litt idag! Sjølvaste fødedagen! Trur det blir dessert.
Sidan vi ikkje hadde mobiltelefon, fekk ingen vite noko før mannen tusla seg heim etterkvart, og kunne ringe frå fasttelefonen. Det var ingen bildemeldingar, inga oppdatering på Facebook og ikkje fødsel bilde for bilde på Snapchat, sikkert like greit.
Denne karen er no over 1.90 høg, breiskuldra, aktiv, søv lite (framleis) og kjekk kar. Naturlegvis!